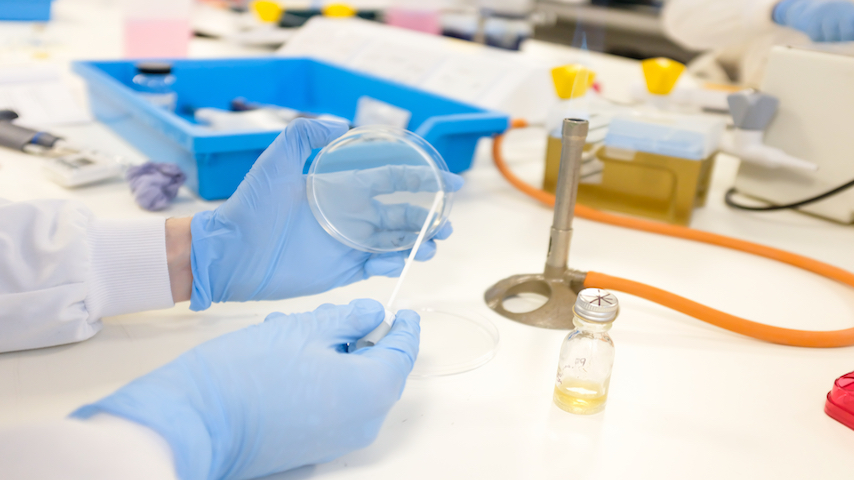
Shutterstock 1664112631 64ee054362f18

The global biotechnology industry as a whole is experiencing remarkable growth and innovation, with its market value predicted to rise from an estimated $1.2 trillion in 2022 to $3.2 trillion by 2030. Biopharmas in particular are fueling biotechnology market growth through their breakthrough advancements in scientific research and the development of novel therapies.
As biopharma companies strive to bring their transformative treatments to market, they face many challenges. Some of the most critical of those is the optimization and management of biologics facilities. There is increasing demand for specialized biologics manufacturing capacity to optimize efficiency and meet stringent regulatory requirements. However, accessing the required infrastructure and capacity can be challenging, especially for smaller and new companies with limited internal resources.
The state of the biopharma market
The vibrant bio pharma industry landscape offers immense opportunities for companies to revolutionize health care and address unmet medical needs. However, amid this exciting growth, the industry also faces unique challenges related to the capabilities and infrastructure of manufacturing sites. To understand the facility-related issues that biopharma companies encounter, it is essential to examine the state of the market and the factors shaping its trajectory.
1. Increasing demand for biologics and production scalability
Biologics offer tremendous potential for treating diseases with high unmet medical needs. As a result, there is a growing demand for biologics worldwide. This surge in demand has led to shortages in capacity being a major issue, particularly in the monoclonal antibody (mAb) space. The capacity issues biologics developers are facing are often connected to one of two main profiles:
- Existing products that are experiencing growth post-approval
- Newly approved products that require large-scale manufacturing in post-launch and the initial year.
Adding to the issue is the need for specialist sterile processing lines for many biologics. Biologics are mostly administered parenterally. This is partly because their sensitive active ingredients are prone to degradation in the gastrointestinal (GI) tract, and because their large molecule size poses bioavailability challenges. As injection bypasses the body’s defenses in the GI system, any treatment administered this way must be processed and filled in a sterile environment to ensure patient safety.
2. Evolving manufacturing technologies
Advancements in bioprocessing technologies, including single-use systems, continuous manufacturing and process automation, have revolutionized biologic production. Such technological advancements offer increased efficiency, flexibility, and productivity in biopharma manufacturing.
However, adopting and integrating these innovative manufacturing approaches into existing facilities can present technical and operational challenges. Moreover, the cost of implementing them might present a barrier too high for many bio pharma manufacturers, especially smaller companies with limited funds.
3. Ensuring compliance and protecting data
Ensuring data integrity and cybersecurity is a significant challenge in biopharma facilities. Manufacturers must establish robust data management systems and implement stringent cybersecurity measures to protect sensitive information, maintain regulatory compliance, and prevent data breaches. Implementing proper data governance practices, encryption protocols, access controls and continuous monitoring helps safeguard critical data throughout its life cycle.
New technologies, such as artificial intelligence or blockchain, have the potential to ensure data security while helping to streamline data collection and analysis. Again, though, the cost of implementing these new technologies and improving connectivity between disparate computer systems within a company might discourage many bio pharma companies from investing for the time being.
4. Global impact
Having a global impact while maintaining environmental, social and governance (ESG) considerations is of paramount importance in today’s world. The bio pharma industry has the potential to revolutionize health care by developing innovative therapies to address unmet medical needs, improve patient outcomes and enhance global health care systems but it is equally crucial for them to operate with a strong commitment to ESG principles.
Sustainability, in particular, is a rising concern for the bio pharma industry, following the signing of the Paris Agreement in 2015 to limit global warming to 1.5℃ above pre-industrial levels. National governments are introducing strict new legislation designed to encourage companies in all industries to reduce their carbon emissions. With this in mind, biopharma companies must explore ways to minimize the environmental footprint of their end products, operations, and supply chains. Sustainable practices, responsible resource management, and ethical decision-making ensure the biopharma industry's long-term viability and have positive societal and environmental implications.
Biopharma companies should also work with contract development and manufacturing organization (CDMOs) that recognize the importance of sustainability and ESG initiatives in the bio pharma industry. The competitive CDMOs should be able to support biopharmas in integrating sustainable practices into their operations, including energy-efficient technologies, waste reduction strategies, and responsible resource management. By collaborating with such CDMOs, biopharmas can align their manufacturing processes with sustainability goals and ESG principles, reducing their environmental footprint and contributing to a more sustainable future.
As biopharma companies strive to bring transformative therapies to patients, they must navigate all of these facility-related challenges. By understanding the obstacles to success and exploring strategies to address them, biotech companies can effectively navigate the complexities in biologics production at scale and drive innovation in the biopharma sector.
Overcoming facility-related challenges
The manufacturing obstacles faced by biopharma companies may seem daunting, but they can be overcome with careful planning, strategic approaches, and collaboration. Adopting the below key strategies can help biotech companies address issues with manufacturing sites:
Design facilities with scalability in mind
Addressing biopharma facility design and scalability issues requires careful planning and foresight and is essential to accommodate current and future needs, such as clinical trial supplies and potential commercial production.
Companies should consider engaging experts in facility design and engineering early in the development process to ensure that sites are purpose-built to meet the specific needs of biologic production. Ensuring that the necessary infrastructure is in place requires biopharmas to evaluate operational capabilities, including cleanrooms, manufacturing capacity, equipment, and technologies.
Designing modular and flexible sites that can be easily scaled up or reconfigured allows for seamless expansion as demand increases. Incorporating innovative technologies, such as single-use systems or continuous manufacturing, can also enhance scalability and efficiency.
Although adapting existing facilities to integrate innovative design and flexibility is possible, this approach can present challenges. Modifications to existing sites can require significant financial investment, are limited by physical and operational limitations, and risk downtime, disruptions and inefficiencies of workflows.
Work with regulatory compliance experts
Compliance with regulatory standards is a paramount concern for biotech companies. To navigate regulatory challenges successfully, it is crucial to engage regulatory experts or consultants who are well-versed in the specific requirements of the target markets. These experts can provide guidance on regulatory strategies, assist in preparing regulatory submissions, and ensure that sites and processes adhere to cGMP and other regulatory guidelines. Building a strong quality assurance and quality control system is also essential to maintain compliance throughout the development and manufacturing processes.
Harness technological advancements
Embracing technological advancements can significantly enhance facility operations and productivity. Companies should stay updated with the latest developments in bioprocessing technologies, automation, and data management systems.
Protecting sensitive data, ensuring data integrity, and maintaining robust cybersecurity measures are critical aspects of biopharma facility operations.
In particular, data integrity and cybersecurity measures are paramount concerns across industries. Staying up to date with technological advancements ensures that effective quality systems are in place and regulatory compliance is maintained. A few examples include:
- Implementing data management systems: Robust data management systems establish a strong foundation for data integrity within facilities. These systems encompass comprehensive data governance practices, ensuring accurate, complete, consistent and reliable data throughout project life cycles. They minimize the risk of data corruption, unauthorized access, and manipulation, enabling reliable decision-making and regulatory compliance.
- Introducing cloud-based security solutions: Biologics development involves handling sensitive and proprietary information, making cloud-based security solutions crucial. These solutions provide enhanced protection against cyber threats and data breaches. With robust encryption, multi-factor authentication, access controls, and continuous monitoring, cloud-based security safeguards data from unauthorized access, loss, or cyber-attacks. Leveraging trusted cloud service providers minimizes the burden of maintaining on-premises security systems, ensuring data confidentiality, integrity and availability.
Find innovative solutions to acquire and develop talent
Building a skilled workforce is crucial for overcoming facility-related challenges, and location plays a crucial role in biotech success. Being situated within a regional biopharma hub (a city or locale where multiple biotechs are already based) offers numerous strategic advantages for drug developers or CDMO partners. These include helping to attract top scientific and technical talent from around the world. The presence of leading research institutions and universities within the hub can also ensure a steady influx of highly skilled professionals with expertise in biopharma manufacturing, process development, and quality control.
Promote collaboration and partnerships
Collaboration and partnerships can play a vital role in overcoming operational hurdles. One valuable resource that can significantly support biopharmas in their efforts is partnering with CDMOs. By forging such collaborations, biopharma companies can leverage pre-existing specialized infrastructures, expertise, and resources. Partnerships allow access to state-of-the-art facilities, cutting-edge technologies, and experienced personnel, which can help bridge the gaps in capabilities and accelerate the development and manufacturing processes.
Facilitating the future of biologics
As the biologics industry continues to evolve, biopharma facilities will remain at the forefront of innovation. The importance of operational capacity that empowers biopharma companies to bring life-changing therapies to patients efficiently, reliably, and ethically cannot be understated. As the industry advances, flexible biopharma facilities will continue to drive progress, enabling the development and manufacturing of safe, effective, and transformative therapies that improve and save lives. .